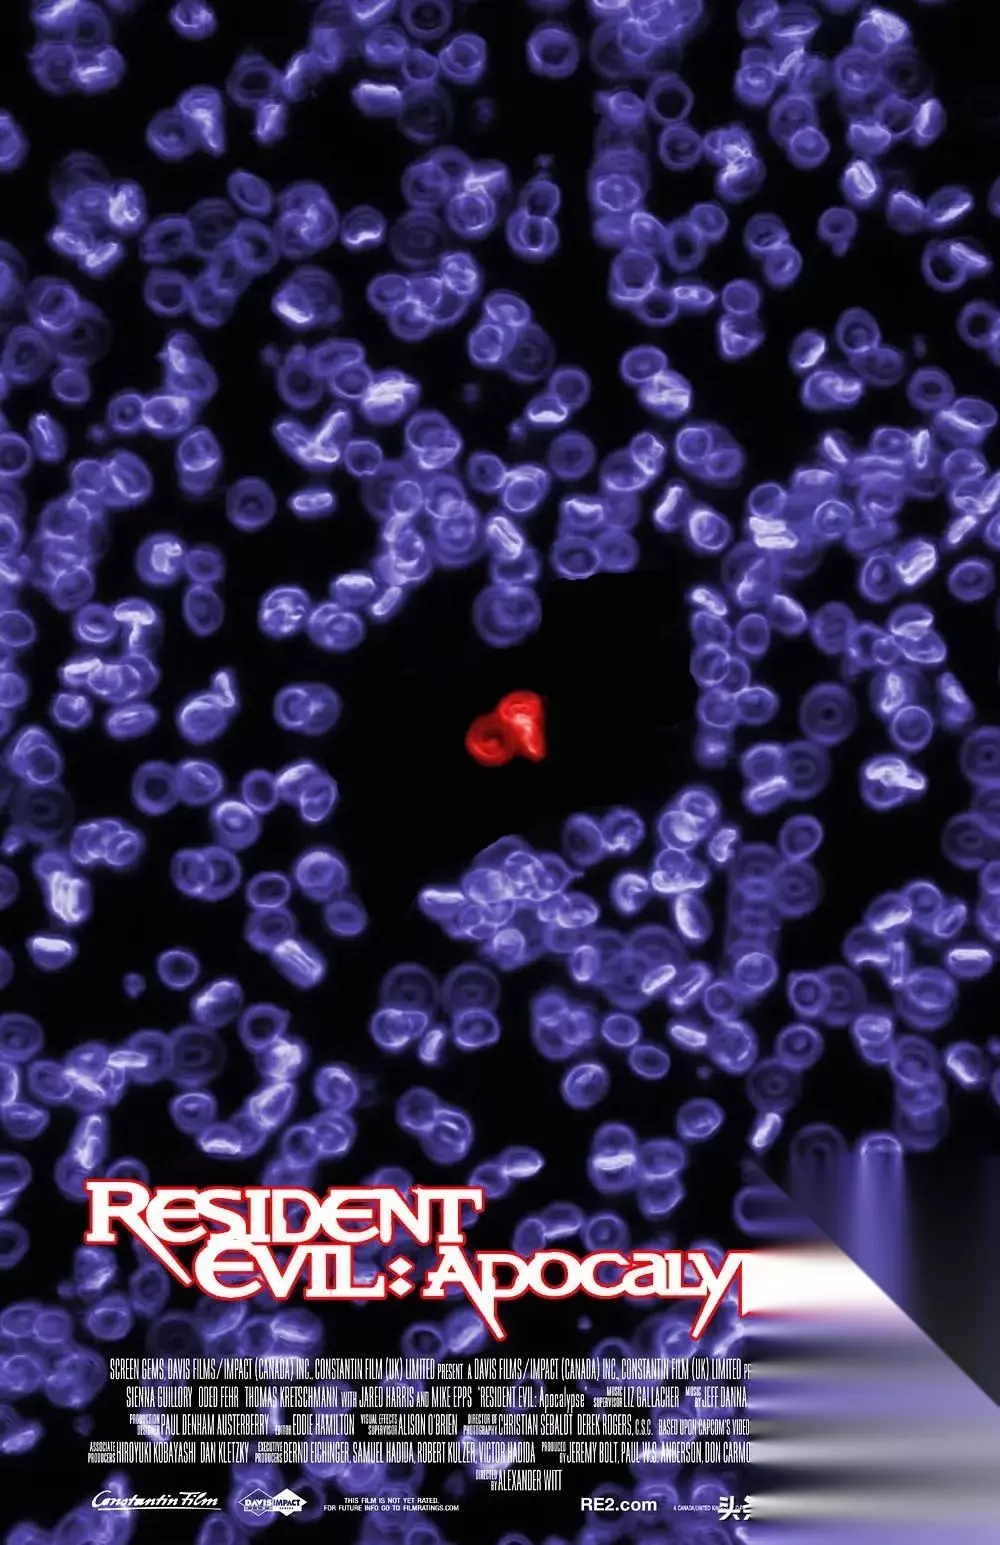

第一部《生化危机》

《生化危机1》 威斯克给一个所谓爱丽丝丈夫的男人,发出了释放T病毒的指令

照片上的两个人记忆都是被植入的 完事以后,再给他植入一段记忆,让他以为自己原本是打算去黑市卖病毒的。把整个事件伪装成一次,纯个人行为导致的灾祸。

盗取T病毒 毕竟,公司不会希望全世界人都知道,病毒是自己故意放的。 事实上,此事绝大部分保护伞公司的内部人员,都一无所知。事发当天,他们一个个,还都在浣熊市地下的蜂巢研究中心正常上班。 没想下一秒钟,这里就成为了人间炼狱。自己则成为了携带病毒的工具。

员工被感染 天启计划一旦启动,艾丽西亚曾经上传到红后系统里的文件,也自动被打开。

红后 前面我们提到了,红后的基础设定是服务公司和保全人类。而艾萨克博士的天启计划,有悖于自己的基础设定,这不是保全人类,是要灭绝人类啊。 所以红后立即做出了隔绝病毒的判断。封锁了蜂巢,并释放出麻醉剂让人们昏迷,不让任何人逃离蜂巢。 红后的行为,出乎了艾萨克的意料,于是派了一支精英特遣队,进行调查。 此时爱丽丝醒来,特遣队告诉她是中了神经毒气,所以才会丧失记忆。

爱丽丝醒来 对其他人也许如此。但对爱丽丝来说,没有记忆是她实验的一部分,只不过,这一次由于红后的神操作,导致没有实验人员就位,爱丽丝自己醒了。 爱丽丝误打误撞,跟着特遣队来到了红后的跟前
经典名场面
特遣队女队员,后面还会再次出现 红后想要阻止病毒的传播,但特遣队此时对病毒还一无所知,因此红后被强制断电关机,导致已经被T病毒感染的丧尸跑出了蜂巢。 后果是什么,你懂的。

后果 关机前,红后对特遣队以及爱丽丝说,你们全都得死。这并不是骂人,而是她提出的解决方案,因为这样,才能保全更多的人类。

红后,以及她的经典台词 了解了蜂巢内的情况以后,艾萨克派出研究小组回收爱丽丝,顺带还收一个被舔食者感染的人类男性——马特。

马特开始变异 马特的身上已经开始发生变异,于是研究人员让他进入了“复仇女神计划”。 所谓复仇女神计划,是保护伞通过一种T病毒寄生虫,对受试者的大脑进行精准控制的项目。所以我们可以看到马特后来成为的追击者,可以指哪打哪。

复仇女神系统 同时,艾萨克博士也将爱丽丝计划推进到了下一个阶段,之前的实验,大多都是拿克隆体在实验室里进行研究,但真正的进化,往往是在自然环境中产生。

爱丽丝计划下一阶段 在艾萨克的眼里,自己是爱丽丝的造物主:我能创造你,我就能毁灭你。他并不担心失去对爱丽丝的控制,所以命人释放了研究室里的爱丽丝。看看自己创造的完美生物,在世界末日的真正表现,究竟如何。 于是,天启日降临的第13个小时,或者说T病毒爆发后的第13个小时,爱丽丝再次苏醒

爱丽丝再次苏醒 【2】 《生化危机2-启示录》的故事开始

《生化危机2-启示录》 电影副标题要叫“启示录”,实际就是“天启计划”的意思 爱丽丝从洁白的实验室跑到浣熊市的大街,发现世界已是一片末日的图景。城市的文明,荡然无存,只剩下了“脏乱差”而已。

浣熊市大街 当然,还有满大街被T病毒感染后的丧尸。他们失去了人类的意识,脑子里只剩下了对食物的饥渴。
病毒包围 此时的保护伞公司开始派人到浣熊市善后,大部分保护伞的员工,其实是不知道天启计划存在的,他们也想搞清楚究竟发生了什么。 当发现疫情已经难以控制时,下令封锁了整个浣熊市。只允许重要的保护伞人员离开,其中就包括最早进行T病毒研究的阿须福德博士。但博士坚持说,必须带上自己的女儿一起走,可她的女儿又偏偏在骚乱中失去了联络。 博士利用CCTV网络找到浣熊市依旧幸存的人,让他们帮自己找女儿,条件则是可以帮助他们离开浣熊市。为什么一定要离开呢,因为保护伞公司马上就要对浣熊市,进行核武器轰炸,毁灭证据。

CCTV 女主角爱丽丝,暴力女警吉尔,保护伞安保人员卡洛斯,痞子LJ,女记者等人接受了博士的任务,前往学校搜救博士的女儿。从而也发现了T病毒的秘密。

爱丽丝,完成了变装

吉尔,太喜欢啦

吸烟哥-卡洛斯

博士的女儿 当他们几乎就要成功逃离时,追击者出现了。

追击者 追击者是谁,还记得第一部里和爱丽丝一起逃出来的那个男人吗,他被感染以后,成为了复仇女神计划的实验品,变异为了更强大的怪物。这种怪物,不仅力大无比,刀枪不入,而且还懂得使用武器。 那么问题就来了,追击者和爱丽丝,都是T病毒变异的产物,究竟谁更加完美呢?保护伞的研究人员们很感兴趣。 于是一场顶尖物种之间的PK开始了,为了公平起见,研究人员还卸掉了追击者的武器,让他们肉搏。 经过一番厮杀,爱丽丝证明了自己才是更强大的物种,但她没有忍心杀死追击者,因为追击者曾经也是人类,更是自己认识的人类,马特。 而马特在最后时刻,也摆脱了保护伞公司的意识控制,拿起武器指向了真正的敌人。掩护爱丽丝等人乘坐直升机,在核H爆来临的最后时刻,逃离了浣熊市。

H爆 不过核爆的冲击波还是导致了坠机。事故中,爱丽丝为了保护博士的女儿失去了生命。 其他人离开以后,事故现场只留下了爱丽丝的“尸体”。艾萨克博士亲自到达现场,确认了“尸体”,并将“尸体”带回了研究所。浣熊市的核H爆也被伪装成了核H电站的事故。
尸体? 爱丽丝真的死了吗?并没有,她体内的T病毒可以让她起死回生。在保护伞公司营养液的浸泡下,三周以后,爱丽丝再次苏醒。

营养液 艾萨克虽然清除了爱丽丝的记忆,但爱丽丝却靠自己意志,恢复了记忆,并记起了实验室里艾萨克博士的脸。 而爱丽丝的这一次重生,更是让她拥有了意念控制的超能力,简直逆天啊。果然,进化就要在激烈的竞争中,才更加有效率。 艾萨克的目的达到了,所以当卡洛斯和吉尔假扮保护伞高层,将爱丽丝救出研究所的时候

卡洛斯是真的保护伞员工,职位是伪造的 他明明可以阻拦,却故意放行,因为他想看看,爱丽丝究竟可以有多大的造诣。

艾萨克的野望 【3】 于是就有了《生化危机3-灭绝》的故事

《生化危机3-灭绝》 爱丽丝并不知道,自己的体内已植入了保护伞公司芯片。只要进入足够近的距离,保护伞公司就可以控制爱丽丝,这也是复仇女神计划的重要研究成果。 与此同时,艾萨克也拿其他的爱丽丝克隆体进行实验,可始终达不到爱丽丝1号的效果。 几年过后,世界彻底被T病毒改变。

感染扩散 绝大部分地区,都已经被丧尸控制,人类要么躲进暗无天日的地下,要么在地面居无定所,苟延残喘。其中有一支队伍,在女汉子克莱尔的带领下,在沙漠地区顽强地活着。当中有两个人还是爱丽丝的熟人——卡洛斯和LJ。

克莱尔 但爱丽丝和吉尔却不在其中。爱丽丝意识到自己始终在保护伞的视线范围内,为了保护其他人的安全,他选离开了其他的人。侵入保护伞公司的电脑系统,躲开卫星定位,让自己在保护伞公司的地图上隐形。

保护伞公司的卫星 一次偶然的机会,爱丽丝发现了一本日记,当中记载了在阿拉斯加,有一个还没被病毒感染的地方:阿卡迪亚。 在与克莱尔、卡洛斯他们的车队相遇后,爱丽丝把这个消息告诉了他们。于是车队出发寻找这片人类最后的净土。

最后一片净土——阿卡迪亚 经过多年的研究,艾萨克博士已经可以开始操纵T病毒的感染体,他派出穿着制服,整齐划一的丧尸部队,定向围剿了克莱尔的车队,并且还近距离让爱丽丝关机。
穿工作服的丧尸 这下爱丽丝总算知道,为什么保护伞总是可以找到自己了。她通过意念烧毁了体内的芯片,反击艾萨克的特勤队。反而顺藤摸瓜,找到了艾萨克在沙漠里的实验基地。

卡洛斯牺牲,幸亏抽上了最后一口烟 这里的直升机正好用来给克莱尔他们去找阿卡迪亚。而爱丽丝自己,则留下来进入了地下的保护伞基地。 艾萨克博士因为被丧尸感染,给自己注入了大剂量的疫苗,从而产生了变异,成为了新的怪物。变异后的艾萨克几乎死不掉,恢复能力比之前见过所有怪物都强,而且攻击距离也长了许多。

博士变异 爱丽丝利用基地内的激光武器,智取了怪物。不过,你懂得,死掉的,只是艾萨克博士的克隆体。 同时,爱丽丝的三观彻底被颠覆,狗G日R的保护伞公司,竟然制造了那么多自己的克隆体进行研究,这是祸害了,多少个自己呀,于是她决定,向保护伞公司发起复仇。

爱丽丝和克隆体87号

那么多克隆体 你们不是有复仇女神计划吗,好啊,让你们看看,什么是真正的复仇女神。 【4】 接着,就进入了《生化危机4-战神再生》的故事 四年后,爱丽丝带领克隆人大军,攻入了保护伞公司位于东京的基地。公司执行主席威斯克本尊,此时就在这里。

东京总部

克隆人的进攻 威斯克见大势已去,乘坐飞机逃出基地,同时启动基地的自毁程序,无数个爱丽丝的克隆体,一瞬之间灰飞烟灭。但是爱丽丝1号,却与他同上了一架飞机。

东京H爆 威斯克也不是省油的灯,做到主席的位置,还是有两把刷子的。他料到了爱丽丝会是最后一个拦截者,拿出早就准备好的疫苗,注射进了爱丽丝的身体。如此一来,爱丽丝的超能力被剥夺,沦为了威斯克的手下败将。当然,威斯克体内也是有T病毒的。即便没有超能力,爱丽丝的战斗能力,也不是一般人可以比肩的。 现在的威斯克自认为可以替代爱丽丝的位置,成为公司的希望。

威斯克 但此时飞机撞向了山体,发生了坠机。 爱丽丝幸存了下来,威克斯怎么样了,不得而知。 从此以后,爱丽丝踏上了寻找最后净土——阿卡迪亚的旅程。 花了6个月的时间,终于找到了传说中坐标位置。却发现,这里只不过是一片廖无人迹的沙滩。看一边停着的飞机,一定有人来过,就是不知道人都去了哪里。

突然,曾经去寻找阿卡迪亚的克莱尔出现了,爱丽丝想着这下总算要真相大白了吧,可是克莱尔却失去了记忆,连爱丽丝都已经不认识了,更别提阿卡迪亚。 爱丽丝带着克莱尔上路,竟然在一座囚禁犯人的大楼上,发现有人在求救,在这里,他们遇到了名叫卢瑟的篮球明星,以及克莱尔的哥哥,克里斯

卢瑟

你有监狱要越吗? 只不过现在的克莱尔已经不记得自己有这个哥哥了。

还有一个重大的发现,就是阿卡迪亚,并不是一个村庄,一座城市,而是一艘巨轮。

真正的阿卡迪亚 爱丽丝来到这里没多久,防御工事被丧尸攻破,原来有一个身高超过2米,外号巨斧行刑者的丧尸夺门而入。 爱丽丝和克莱尔精诚合作,用填装硬币的散弹枪干掉了行刑者

行刑者 幸存者们最后通过下水道逃到了海边。幸存下来的,只有爱丽丝,克莱尔,还有她哥哥克里斯三人。卢瑟与众人失散。 爱丽丝等人乘坐小艇登上了阿卡迪亚号邮轮。却发现邮轮上空无一人。但当他们看到保护伞公司的标志,事实真相也渐渐浮出水面,克莱尔的记忆也慢慢恢复。阿卡迪亚,不过是另一个骗局和陷阱而已。 在这里守株待兔的,是再次变异过的威斯克。而之前那些消失的人,许多都成为了保护伞公司的实验品,被装在一个个玻璃器皿里。

威斯克再次变异,G病毒,是你吗? 废了一番周折,威斯克败下阵来。 爱丽丝等人本以为,打败威斯克,夺下阿卡迪亚号,救出被关押的人,人们就可以将阿卡迪亚号当成生命的方舟,生活重新开始

新的生活开始了?

K-mart,好看 但是,保护伞公司却一刻也不会让他们停歇。 浣熊市事件后失踪的暴力女警吉尔,这一次,却以保护伞公司安全总监的身份示人,对阿卡迪亚上的人展开了围捕。

吉尔变成了安全总监 【5】 于是就有了《生化危机5-惩罚》的故事。

《生化危机5-惩罚》 爱丽丝被保护伞公司,抓到了位于俄罗斯北部冰层之下的,一个研究基地。 这个基地专门用于研究和展示T病毒的武器化。在这里,模拟了世界各地城市街区的景象,用途是展示T病毒武器的威力,用于军火售卖。 要逃出这个水下基地,谈何容易,除非有贵人相助。可爱丽丝怎么也想不到,这次要帮自己逃出去的,竟然是威斯克。他的理由是,人类即将面临灭绝,爱丽丝则是人类最后的希望。 所以威斯克派出了艾达王,里昂,还有熟人卢瑟等人。来协助爱丽丝逃出基地。

艾达王,冰冰惊艳啦

酱油4人组,卢瑟(左1),里昂(左2) 虽然不可思议,但是总要逃出去的,这时候也不介意多一些帮手。 基地里,到处都是克隆人,他们的记忆全都是人工植入的,一段不一样的记忆,就是一段不一样的人生。

克隆人 基地里,也见识了各种各样的T病毒怪物,更准确地说,是T病毒武器。

T病毒武器 但最终决战的BOSS,却是两张熟脸,一个是被意识控制的吉尔,一个是第一部里女队员的克隆体。

吉尔大变身啦

克隆人女队员 打败她们之后,爱丽丝等人来到了威斯克正被丧尸军团围攻的总部。威斯克重新给爱丽丝注射了T病毒,让她恢复了超能力。 他的说辞是,还得是你啊,你是拯救人类命运最后的武器。

重新注射了T病毒 外面的世界确实大变天了,丧尸经过几轮变异后,已经鸟枪换炮,有天上飞的,有墙上爬的,连最普通的丧尸至少也可以跑了。人类的命运,的确到了最危难的时刻。



华盛顿之战 可是人类的抵抗,还不到一年的时间,就宣告溃散。

消失的华盛顿之战, 华盛顿到底发生了什么呢?以后有机会再说吧 《生化危机6-终章》的故事开始

《生化危机6-终章》 威斯克说的那些鬼话,你听听就好了。他依旧只是在执行,幕后黑手艾萨克博士的“爱丽丝计划”而已。重新将超能力归还给爱丽丝,也只是计划的一部分。所谓拯救人类,也只是灭绝人类的前奏。 只不过,爱丽丝又一次成功逃离了。 到了T病毒爆发后的第10年,地表上仅存活下来4472人。再过48小时,艾萨克当初定下的大清洗计划,就将迎来最终的胜利。

地表仅存4472人 只是他视若珍宝的爱丽丝,总也舍不得杀死的爱丽丝,却依旧没有得到完全的控制。 令人想不到的是,人工智能红后找到了爱丽丝,告诉她人类即将灭绝的消息,并有零有整地公布了表上仅存的人类数量。 更扎心的是,她说10年前本就应该阻止这场浩劫,但是她们俩都失败了。 的确,要不是爱丽丝等人,10年前在浣熊市蜂巢关闭了红后,可能也不至于T病毒那么迅速地泄漏。 爱丽丝可以不相信红后,但她相信现在世界上发生的一切,跟自己脱不了关系。 红后告诉爱丽丝,在浣熊市地下蜂巢,有保护伞公司研发的一种以风为媒介的T病毒疫苗。这是什么概念呢,只要打碎这瓶疫苗,大风一吹,所到之处,T病毒感染的怪物就得灭绝,就可以拯救全世界。 很显然,这是艾萨克博士打算在地表人类都灭绝以后,让保护伞高层重返地表时使用的救世神药。 那么重要的消息,一定要等到人类只剩下4位数的时候,再告诉爱丽丝吗? 原因可能是,10年前红后关闭蜂巢时,艾萨克就对红后的数据做了修改,红后花了很长的时间,才挖掘到了这个至关重要的信息。 最后2天的时间,爱丽丝索性放手一搏。 她赶往浣熊市,路上竟遇见了艾萨克博士,爱丽丝这才知道,之前的艾萨克原来也是个克隆体。

艾萨克的克隆体 现在的这个,正打算将一支丧尸军团引到浣熊市。为最后的大清洗做准备。 爱丽丝想办法提前一步到达了浣熊市,在这里,你猜她见到了谁? 竟然是克莱尔,原来在阿卡迪亚号上被捕后,她从飞机上逃了出来,飞机是飞往浣熊市的,所以她也逗留在了这里。

浣熊市 爱丽丝带着一伙有生力量,进入了蜂巢,这里机关重重,还有各种危险的感染生物,但是在红后的帮助下,爱丽丝到达了蜂巢的核心控制室。威斯克也提前唤醒了,保护伞公司最重要的两个大股东。一个是艾萨克博士的本体,一个是马库斯的女儿艾丽西亚。

艾萨克博士的本体

艾丽西亚 一切的真相,总算水落石出。 爱丽丝终于知道了,T病毒是保护伞公司故意释放的,知道了艾萨克的“天启计划”。 而令她再次颠覆三观的,是自己的身世——艾丽西亚的克隆体。

艾丽西亚告诉爱丽丝,你无须将自己看成是一个克隆体,你做得比其他人都要好,你是人类真正的希望。而我才是这一切的祸根。此事因我而起,此事由你而终,也不失为一种更好的归宿。 缓过神来以后,爱丽丝继续追踪艾萨克博士以及他手中的疫苗。 最终,博士并没有死在爱丽丝的手中, 而是死在了自己克隆体的手中,克隆体又死在了丧尸的口中,种什么因,就会得什么果,艾萨克博士,生动地为我们上了一课。
艾萨克博士克隆体 而爱丽丝也在黎明来临之前,打碎了疫苗的瓶子。尽管她知道疫苗对体内有T病毒的自己意味着死亡,她依旧选择了亲自终结这一切。

可是,疫苗只是杀死了T病毒,却没有杀死爱丽丝,反而将爱丽丝变回了一个正常人。 艾丽西亚,也将自己的记忆下载后传输给了爱丽丝,从此爱丽丝的回忆里,不再只是充斥着僵尸,杀戮和人性,她也和所有普通人一样,拥有了一段完整的人生。

彩蛋 猜猜爱丽丝小时候是谁?

小爱丽丝

小爱丽丝和她妈妈

然后。。。
boom
2025-12-27 09:28:48 发布在
热门游戏攻略
说点好听的...
收藏
0
0